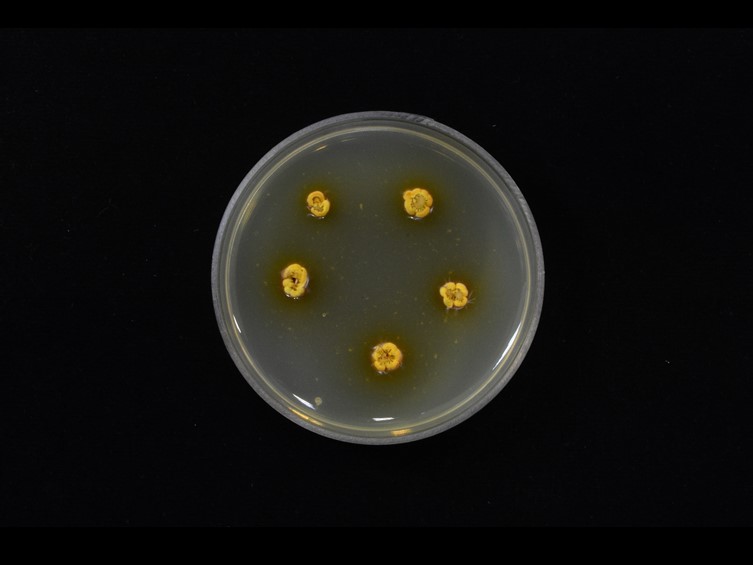

Holotype:
THAILAND, Nakhon Ratchasima Province, Khao Yai National Park, 31 May 2018, J. Luangsa-ard, K. Tasanathai, S. Mongkolsamrit, W. Noisripoom, holotype BBH 47453, ex-type living culture BCC 88308.
Habitat:
Buried in soil.
Host:
On Coleoptera.
Description:
 Stromata solitary or multiple, cylindrical, gradually tapering toward the apex, brownish orange to moderate orange, arising from head, thorax and abdomen of Lycidae larvae (Coleoptera), 4–18 mm long. Stipes cylindrical, smooth, brownish orange, 0.5–1 mm wide. Ascomata distinctly subterminal, developed lateral cushion on stipes, slightly pulvinate, densely packed
Stromata solitary or multiple, cylindrical, gradually tapering toward the apex, brownish orange to moderate orange, arising from head, thorax and abdomen of Lycidae larvae (Coleoptera), 4–18 mm long. Stipes cylindrical, smooth, brownish orange, 0.5–1 mm wide. Ascomata distinctly subterminal, developed lateral cushion on stipes, slightly pulvinate, densely packed  perithecia, 1.5–2 mm diam, 1.5 mm thick. Perithecia pseudo-immersed, pyriform, 380–480 × 220–320 μm.
perithecia, 1.5–2 mm diam, 1.5 mm thick. Perithecia pseudo-immersed, pyriform, 380–480 × 220–320 μm.  Asci cylindrical, up to 360 μm long, 5–8 μm wide with asci caps, 2–5 × 5–6 μm.
Asci cylindrical, up to 360 μm long, 5–8 μm wide with asci caps, 2–5 × 5–6 μm.  Ascospores cylindrical, breaking into 32 small truncate part-spores, 5–10 × 1–1.5 μm. Asexual morph: Synnemata multiple, cylindrical, brownish orange to pale yellow, up to 8 mm long, 0.5–1 mm wide, occasionally located at the terminal of stipe connected with the ascomata.
Ascospores cylindrical, breaking into 32 small truncate part-spores, 5–10 × 1–1.5 μm. Asexual morph: Synnemata multiple, cylindrical, brownish orange to pale yellow, up to 8 mm long, 0.5–1 mm wide, occasionally located at the terminal of stipe connected with the ascomata.  Conidiogenous cells hirsutella-like, monophialidic or polyphialidic, swollen basal portion, 4–15 × 2–5 μm, gradually tapering from the base to the apex up to 8 μm long.
Conidiogenous cells hirsutella-like, monophialidic or polyphialidic, swollen basal portion, 4–15 × 2–5 μm, gradually tapering from the base to the apex up to 8 μm long.  Conidia hyaline, smooth-walled, fusoid, 4–8 × 0.5–1 μm.
Conidia hyaline, smooth-walled, fusoid, 4–8 × 0.5–1 μm.
Culture characteristics:
Colonies on PDA attaining a diam of 10 mm in 30 d, strong orange yellow, reverse deep orange yellow.
Colonies on PDA attaining a diam of 10 mm in 30 d, strong orange yellow, reverse deep orange yellow.  Conidiogenous cells syngliocladium-like, phialidic, cylindrical to subcylindrical basal portion, slightly curved, 5–15 × 1.5–2 μm, forming a short neck up to 3 μm long.
Conidiogenous cells syngliocladium-like, phialidic, cylindrical to subcylindrical basal portion, slightly curved, 5–15 × 1.5–2 μm, forming a short neck up to 3 μm long.  Conidia hyaline, smooth-walled, falcate, slightly truncate at the ends, 8–10 × 2–3.5 μm.
Conidia hyaline, smooth-walled, falcate, slightly truncate at the ends, 8–10 × 2–3.5 μm.
Reference:
Mongkolsamrit S, Noisripoom W, Tasanathai K, et al. (2024). Uncovering cryptic species diversity of Ophiocordyceps (Ophiocordycipitaceae) associated with Coleoptera from Thailand. Fungal Systematics and Evolution14: 223–250.
DOI: https://doi:10.3114/fuse.2024.14.15Species |
Strain |
Compound |
Pubchem CID |
Biological activity |
Reference |
|---|
|
Strain |
|---|